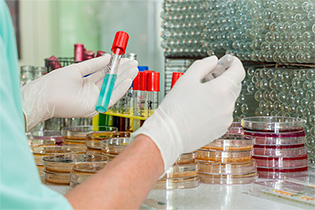

Ornament - мобильное приложение для хранения и обработки результатов анализов
У всех людей в какой-то момент появляется необходимость следить за своим здоровьем: сдавать анализы, которые необходимо показывать врачу, чтобы он сделал определенные выводы о том, какие проблемы могут появиться в скором времени и что с этим вообще делать.
У всех людей в какой-то момент появляется необходимость следить за своим здоровьем: сдавать анализы, которые необходимо показывать врачу, чтобы он сделал определенные выводы о том, какие проблемы могут появиться в скором времени и что с этим вообще делать.
Да, людям, у которых со здоровьем в настоящий момент все в порядке, необходимо хотя бы раз в год делать полный анализ крови, потому что показатели биомаркеров много чего могут рассказать опытному специалисту.
Даже простым обывателям без медицинского образования, скорее всего, известно, что если у вас в крови продолжительное время наблюдается превышение уровня мочевой кислоты, то это в конце концов может привести к подагре - крайне неприятному заболеванию, сопровождающемуся очень сильными болями в суставах. А ведь если вовремя сдавать анализы, то превышение уровня можно вовремя распознать и принять соответствующие меры: изменить режим питания, принимать таблетки, корректирующие уровень мочевой кислоты.
Также известно, что при низком уровне витамина D в крови (а это наблюдается у очень большого количества народа, особенно в странах, где редко светит солнце) усугубляются хронические заболевания, появляется подверженность инфекциям, понижается уровень серотонина в мозгу (как следствие - плохое настроение, депрессия), возникает постоянная усталость, начинают выпадать волосы.
Низкий уровень витамина B12 (это часто случается у людей, которые едят мало красного мяса) - повышенный риск сердечно-сосудистых заболеваний, слабость, головокружения, проблемы с ногами.
Люди, которые ответственно относятся к своему здоровью, знают, что регулярная сдача анализов - практически необходимое условие того, чтобы предупредить появление многих заболеваний и дожить до пенсии, возраст получения которой, как известно, был заметно увеличен.

А теперь переходим к главному вопросу: сдавать-то мы анализы сдаем, а вот как дальше это все хранить? Причем желательно не просто хранить, а иметь эти данные в удобном виде, чтобы можно было анализировать динамику результатов.
Я этим вопросом задался давно. Сначала, когда результаты выдавали в бумажном виде, их сканировал и хранил в определенной папочке. Потом, когда появились облачные сервисы, стал хранить сканы в Evernote, тем более что и результаты стали присылать в электронном виде в формате PDF, так что можно было уже ничего не сканировать.
Но пользоваться этим в таком формате все равно очень непросто: если требовалось проверить, какой уровень того или иного биомаркера был столько-то лет назад, приходилось в программе шерстить эти бумажки, на что уходило немало времени, потому что они у меня просто лежали всем скопом и даже не были систематизированы по датам (дату приходилось смотреть в результатах анализа).
Начал искать, какие программы помогают более систематизированно подходить к хранению результатов анализов. Перебрал несколько штук. Те, в которых результаты предлагалось вводить вручную, сразу отмел: это же с ума сойти - вручную все вбивать! Причем при ручном вводе такого количества самых разномастных данных неминуемо будут ошибки, которые могут сильно исказить картину (попробуй где-нибудь нолик пропустить или случайно добавить - сразу получится полный дурдом).
Там ведь результаты как выводятся? Ну вот как-то так. И такого может быть несколько страниц. Нет, вводить вручную - ни за что!

Были программы, которые предлагали автоматическое распознавание результатов, но там, во-первых, не поддерживался русский язык, а, во-вторых, даже в тех, где поддерживался, точность результатов была крайне низкой - еще хуже, чем при ручном вводе.
Некоторое время назад мне посоветовали бесплатное приложение Ornament (есть под iOS и под Android) - это новая российская разработка, которая поддерживает русский язык. Разумеется, я сразу ее скачал и стал тестировать.
Интерфейс у программы очень простой: снизу идут закладки "Анализы", "Монитор", "Настройки". В "Анализах" крупный плюсик - для добавления данных.

Можно сфотографировать бумажные результаты, загрузить фото, отправить в виде письма, импортировать PDF.

Импорт PDF делается следующим образом: нужно в файловом менеджере выделить от одного до десяти файлов PDF (у каждого может быть до десяти страниц), после чего нажать "Поделиться" и выбрать в списке приложение "Орнамент".
Загрузил с десяток PDF и одно изображение JPG. Система задумалась. Если ткнуть на загружаемый документ, то там появляется надпись о том, что кроме автоматического распознавания каждая оцифровка дополнительно проверяется и корректируется человеком, поэтому загрузка может занимать до двух дней. Человеком?!! Серьезно?!! Это ж какой штат они должны держать? Впрочем, эти вопросы зададим потом, сначала посмотрим, как оно работает.

На самом деле распознавание у них обычно происходит значительно быстрее двух дней. У меня самое быстрое распознавание было сделано за полчаса, самое медленное - часа за три.
Ну вот дождался - появились результаты. Программа сама отслеживает и фиксирует дату анализов.

Захожу в общий анализ крови, сверяю с документом. Слушайте, все точно, цифра в цифру! И результаты выводятся в удобном виде: значения, выходящие за референсные, подсвечиваются.

По каждому параметру можно посмотреть график с историей изменений.

Также в разделе "Монитор" показываются мини-графики всех биомаркеров.

В мониторинге можно разбивать результаты на типы исследования (биохимия крови, гормональные исследования и так далее), также можно отдельно выводить отклонения - это тоже очень и очень удобно.

Я туда для начала занес только российские результаты - из "Инвитро" и еще каких-то клиник.
Ну и решил проверить, справится ли система с испанскими результатами анализов, которые выглядят как-то так.

Вообще, у них официально заявлена поддержка только русского и английского языков. Однако результаты на украинском и белорусском языках также заносятся в 99% случаев.
Ну, посмотрим, как они справятся на испанском: все-таки биомаркеры здесь пишутся в основном на латыни, по идее, должны распознать, учитывая обработку людьми.
А и правда, распознали практически все!

Что самое интересное и удивительное, программа правильно обрабатывает маркеры в разных системах измерений и строит совершенно корректный график! Вот, смотрите: старые значения - в мкмол/л, новые - в мг/дл! И тут еще можно и самому конвертировать одни единицы измерения в другие.

Настройки приложения.

Программа умеет поддерживать несколько профилей - например, членов семьи.

Есть возможность вручную корректировать референсные диапазоны.

Раздел техподдержки. Здесь можно задавать вопросы, также сюда приходят письма о результатах распознавания.

Если какое-то значение система не сумела распознать, об этом пишется. Ну и для такого случая есть возможность ручного ввода, если этот параметр для вас важен.

Ну, вот вроде и все. Честно говоря, я поражен. Совершенно не ожидал, что могут существовать приложения такого уровня. Здесь же можно также собирать и хранить результаты анализов, например, ребенка. Также родители в возрасте свои обследования, как правило, куда-то засовывают и не помнят куда - это все можно практически автоматически занести, хранить и отслеживать в одном приложении.
Также очень важный момент: люди редко делают обследования в одном и том же месте. Как правило, это делается в разных клиниках и разных лабораториях, так что нигде не будет полной картины обследований. А с данным приложением будет именно полная картина, да еще и в очень удобном для изучения виде.
Теперь ответим на вопрос, почему это приложение бесплатное. Вот что пишут разработчики приложения на своем сайте.

Ну то есть понятно: пока приложение бесплатное, а когда они наберут соответствующую базу пользователей, то введут монетизацию - скорее всего, в виде оплаты за какие-то уникальные функции и специальные возможности.
Разумеется, многих пользователей волнует вопрос сохранности персональных данных. Я поинтересовался, как там все устроено. Данные между приложением и сервером передаются по зашифрованному каналу и хранятся деперсонализованно. (Я так понимаю, что при этом указываются только пол и возраст.)
Ну и в следующих версиях разработчики обещают добавить для пользователей возможность указывать, какие именно данные вообще не должны храниться на сервере.
Отличное приложение, понравилось чрезвычайно. А что оно еще и испанские анализы сумело должным образом распознать и занести - это просто совершенно замечательно!
На почту пришло:
(То, что не вышло)
➖ Не удалось обработать снимок с вашими лабораторными анализами. Причина: Ни один тест не распознан
В частности:
Отсутствуют количественные показатели. На данный момент нет возможности это указывать автоматически, но мы работаем над этим.
➖ Не удалось обработать снимок с вашими лабораторными анализами. Причина: Ни один тест не распознан
В частности:
На данный момент тесты на аллергены не поддерживаются.
➖ Не удалось обработать снимок с вашими лабораторными анализами. Причина: Ни один тест не распознан
В частности:
Отсутствуют количественные показатели. На данный момент нет возможности это указывать автоматически, но мы работаем над этим.
➖ Не удалось обработать снимок с вашими лабораторными анализами. Причина: Ни один тест не распознан
В частности:
На данный момент тесты на аллергены не поддерживаются.
➖ Не удалось обработать снимок с вашими лабораторными анализами. Причина: Ни один тест не распознан
В частности:
На данный момент тесты на аллергены не поддерживаются.
➖ Не удалось обработать снимок с вашими лабораторными анализами. Причина: Ни один тест не распознан
В частности:
На данный момент тесты на аллергены не поддерживаются.
➖ Не удалось обработать снимок с вашими лабораторными анализами. Причина: Ни один тест не распознан
В частности:
Отсутствуют количественные показатели. На данный момент нет возможности это указывать автоматически, но мы работаем над этим.
С уважением,
команда Орнамента
(А Это вышло)
Результаты обработки ваших анализов:
➕Натрий, сыворотка и 2 других
➕Hepatitis B virus, поверхностный антиген качественно
➕Антитела к Hepatitis C virus IgG+IgM, качественно
➕Гематокрит и 26 других
➕Антитела к Ascaris lumbricoides IgG, качественно
➕Антитела к Giardia lamblia IgG+IgA+IgM, качественно
➕Лактатдегидрогеназа-1
➕Аланинаминотрансфераза и 3 других
➕Простатический специфический антиген, общий и 2 других
➕Альбумин и 11 других
➕Staphylococcus saprophyticus, влагалище
➕Аланинаминотрансфераза и 23 других
➕Гематокрит и 29 других
➕Аланинаминотрансфераза и 16 других
➕Гематокрит и 30 других
➕Аланинаминотрансфераза и 16 других
➕Гематокрит и 21 других
ПС: спасибо, что нашли ошибку 😄
Ниже рассказала, в чем было дело.
1. Приложение бесплатное. На чем зарабатывают разработчики? Или планируют заработать?
2. Распознавание текста возможно силами смартфона, но мы отправляем это на сервер.
Видимо, все пошли тестировать прогу и положили сервис.
Несколько часов уже висят в распознавании документы. Представляю, сколько там после этого поста на них бумажек свалилось 😄
Проверяют на конечном этапе обработки все равно люди, конечно. На обработку мы в правилах указали 48 часов, но в реальности зависит от величины очереди - среднее значение несколько часов, но бывает и пара минут для очень типичных бланков.
Но однозначно нужна возможность экспорта данных в каком-нибудь вменяемом формате.
Вполне могут монетизировать и доступ к статистике для всяких клиник. Подготовка сводного отчета за период по параметрам по запросу того или иного специалиста. Но это опять же, скорее плюс, чем минус. За обзор спасибо, попробуем поизучать.
по почте добавляет
Но не все записи и картинки доступны в аппликухе, за какими-то надо в портал клиники лезть.
И как они собираются соблюдать все прелести трансграничной передачи персональных данных (при всей их деперсонификации) в рамках 152-ФЗ, в рамках которого данные о здоровье это особая категория ПД с повышенным режимом правовой защиты.






